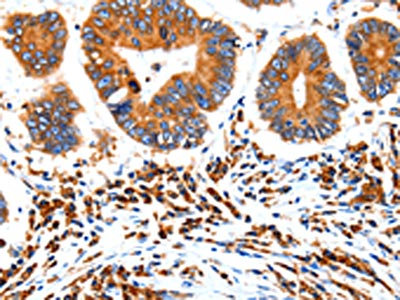

HCN1 Antibody
-
中文名稱:HCN1兔多克隆抗體
-
貨號:CSB-PA202569
-
規(guī)格:¥1100
-
圖片:
-
The image on the left is immunohistochemistry of paraffin-embedded Human thyroid cancer tissue using CSB-PA202569(HCN1 Antibody) at dilution 1/80, on the right is treated with synthetic peptide. (Original magnification: ×200)
-
The image on the left is immunohistochemistry of paraffin-embedded Human colon cancer tissue using CSB-PA202569(HCN1 Antibody) at dilution 1/80, on the right is treated with synthetic peptide. (Original magnification: ×200)
-
Gel: 8%SDS-PAGE, Lysate: 40 μg, Lane 1-2: Human brain malignant glioma tissue, mouse brain tissue, Primary antibody: CSB-PA202569(HCN1 Antibody) at dilution 1/1500, Secondary antibody: Goat anti rabbit IgG at 1/8000 dilution, Exposure time: 2 minutes
-
-
其他:
產(chǎn)品詳情
-
Uniprot No.:
-
基因名:
-
別名:BCNG-1 antibody; BCNG1 antibody; Brain cyclic nucleotide gated channel 1 antibody; Brain cyclic nucleotide-gated channel 1 antibody; HAC 2 antibody; HAC2 antibody; HCN1 antibody; HCN1_HUMAN antibody; Hyperpolarization activated cyclic nucleotide gated potassium channel 1 antibody; Potassium channel; voltage-gated; brain; 1 antibody; Potassium/sodium hyperpolarization activated cyclic nucleotide gated channel 1 antibody; Potassium/sodium hyperpolarization-activated cyclic nucleotide-gated channel 1 antibody
-
宿主:Rabbit
-
反應(yīng)種屬:Human,Mouse,Rat
-
免疫原:Synthetic peptide of Human HCN1
-
免疫原種屬:Homo sapiens (Human)
-
標記方式:Non-conjugated
-
抗體亞型:IgG
-
純化方式:Antigen affinity purification
-
濃度:It differs from different batches. Please contact us to confirm it.
-
保存緩沖液:-20°C, pH7.4 PBS, 0.05% NaN3, 40% Glycerol
-
產(chǎn)品提供形式:Liquid
-
應(yīng)用范圍:ELISA,WB,IHC
-
推薦稀釋比:
Application Recommended Dilution ELISA 1:2000-1:10000 WB 1:1000-1:5000 IHC 1:50-1:200 -
Protocols:
-
儲存條件:Upon receipt, store at -20°C or -80°C. Avoid repeated freeze.
-
貨期:Basically, we can dispatch the products out in 1-3 working days after receiving your orders. Delivery time maybe differs from different purchasing way or location, please kindly consult your local distributors for specific delivery time.
-
用途:For Research Use Only. Not for use in diagnostic or therapeutic procedures.
相關(guān)產(chǎn)品
靶點詳情
-
功能:Hyperpolarization-activated ion channel exhibiting weak selectivity for potassium over sodium ions. Contributes to the native pacemaker currents in heart (If) and in neurons (Ih). May mediate responses to sour stimuli.
-
基因功能參考文獻:
- Polymorphism of HCN1 is associated with breast cancer. PMID: 28178648
- Study presents cryo-electron microscopy structures of the human HCN1 channel in the absence and presence of cAMP at 3.5 A resolution. HCN channels contain a K(+) channel selectivity filter-forming sequence from which the amino acids create a unique structure that explains Na(+) and K(+) permeability. PMID: 28086084
- A new mode of regulating HCN1 trafficking: through the use of a di-arginine ER retention signal that monitors processing of the channel in the early secretory pathway. PMID: 25142030
- de novo HCN1 point mutations cause a recognizable early-onset epileptic encephalopathy in humans PMID: 24747641
- acute abrogation of HCN1-FLNa interaction in neurons, with the use of decoy peptides that mimic the FLNa-binding domain of HCN1, abolishes the punctate distribution of HCN1 channels in neuronal cell bodies PMID: 24403084
- Studies suggest that HCN1 channels may be therapeutic targets for treatment of depressive disorders. PMID: 23033536
- Wild-type presynaptic HCN1 channel function is persistently decreased following seizures. PMID: 23077068
- HCN1 channels make an important contribution to the maintenance of spontaneous burst activity in embryonic cortical neuron cultures. PMID: 22094222
- Hyperpolarization-activated currents are smaller and slower, input resistances are higher, and membrane time constants are longer in HCN1-deficient than in HCN1-expressing neurons of the ventral cochlear nucleus. PMID: 21562186
- Genetic analysis in 48 Sudden unexpected death in epilepsy cases identified six novel and three previously reported nonsynonymous (amino acid changing) variants in HCN1 , HCN2, HCN3 and HCN4. PMID: 21615589
- increasing cAMP levels in cells antagonized the up-regulation of HCN1 channels mediated by a TRIP8b construct binding the CNBD exclusively. PMID: 21504900
- Human HCN1 hyperpolarization activated current (Ih) amplitude is rapidly enhanced after establishment of the whole-cell configuration in HEK293 cells. PMID: 20806410
- Observational study of gene-disease association and gene-environment interaction. (HuGE Navigator) PMID: 20145138
- Helical secondary structure of the external S3-S4 linker of this pacemaker channel is examined and affects its activation PMID: 12668666
- HCN1 and HCN2 expression were measured using in situ hybridization and immunocytochemistry in hippocampi; the expression of HCN isoforms is dynamically regulated in human as well as in experimental hippocampal epilepsy PMID: 12890777
- In HCN1, the amino acid substitution A881T was identified in one idiopathic generalized epilepsy patient. PMID: 17931874
- The polymorphism rs10941679 near HCN1/MRPS30 was also associated with percent dense area in breast cancer. PMID: 19232126
- Observational study of gene-disease association. (HuGE Navigator) PMID: 19232126
- Observational study of gene-disease association. (HuGE Navigator) PMID: 18454440
- Observational study of gene-disease association. (HuGE Navigator) PMID: 17931874
- Observational study of gene-disease association. (HuGE Navigator) PMID: 18081024
顯示更多
收起更多
-
相關(guān)疾病:Epileptic encephalopathy, early infantile, 24 (EIEE24)
-
亞細胞定位:Cell membrane; Multi-pass membrane protein.
-
蛋白家族:Potassium channel HCN family
-
組織特異性:Detected in brain, in particular in amygdala and hippocampus, while expression in caudate nucleus, corpus callosum, substantia nigra, subthalamic nucleus and thalamus is very low or not detectable. Detected at very low levels in muscle and pancreas.
-
數(shù)據(jù)庫鏈接:
Most popular with customers
-
-
YWHAB Recombinant Monoclonal Antibody
Applications: ELISA, WB, IHC, IF, FC
Species Reactivity: Human, Mouse, Rat
-
Phospho-YAP1 (S127) Recombinant Monoclonal Antibody
Applications: ELISA, WB, IHC
Species Reactivity: Human
-
-
-
-
-